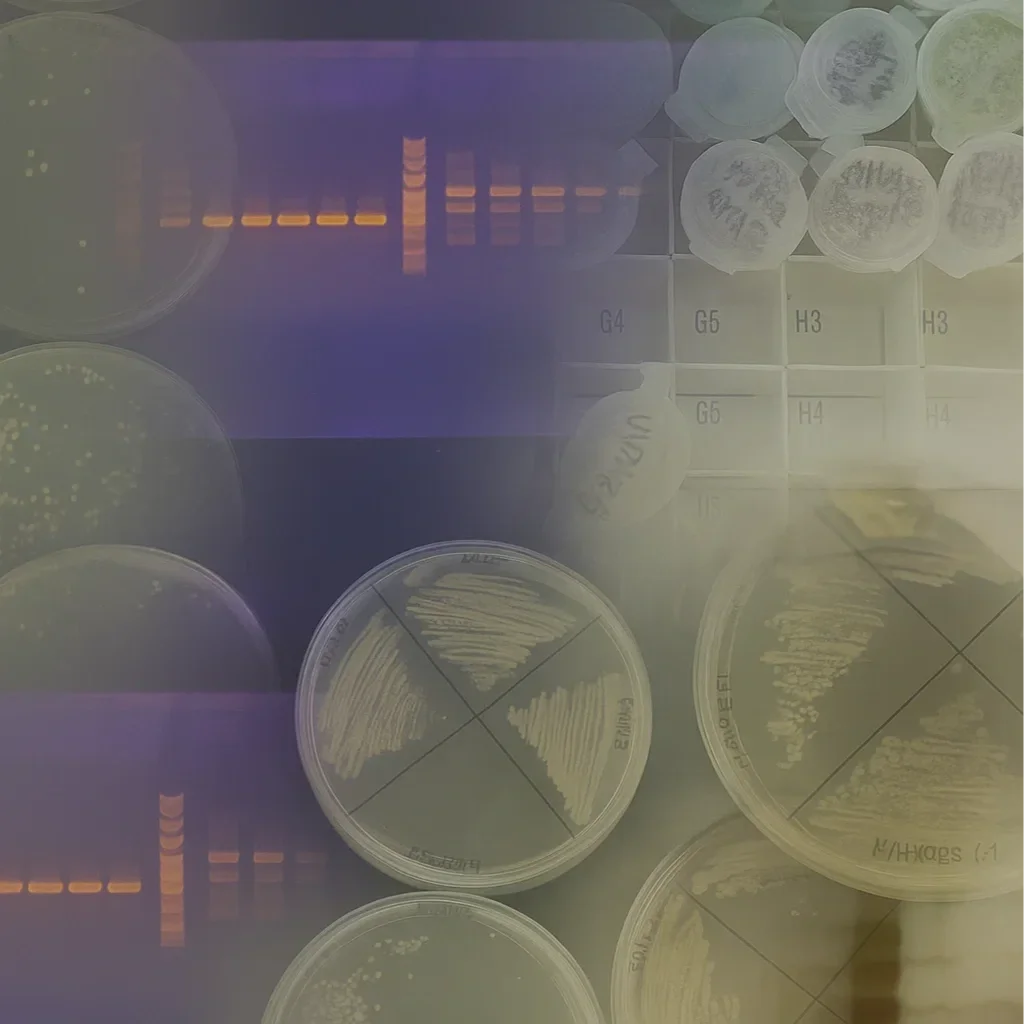

Enepret combines wet-bench research expertise with a diverse network of business and technical consultants to deliver life sciences solutions for industry and government, supporting the successful execution of complex projects.
Synthetic biology
Pioneers in the microbial and plant synthetic biology space. While having its own technology platforms for production of valuable molecules, like terpenes, we have been a part on projects for the production of a variety of molecules.
BIOINDUSTRIAL PRODUCTION AND FERMENTATION
Successfully scaled from bench-top to thousands of liters of fermentation. Deep knowledge of yeast fermentation and other microbes.
Vaccine adjuvants
Experience in preclinical assessment, support identification, and technology transfer. A network of expertise in transitioning to clinical production and evaluation. A history of strong support from the National Institutes of Health and academic collaborations.
Let’s work together
Enepret is ready to help with projects needing consultation, contract research development, and teaming opportunities for new and existing programs.